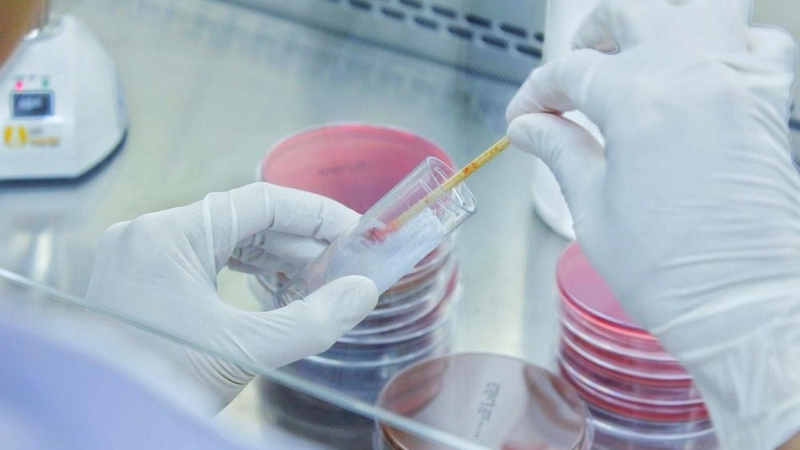
Tìm hiểu nguyên nhân và cách điều trị khi bị khạc đờm ra máu 4

Từng làm ở Viện ISDS, nhiều năm cộng tác với CDC Thái Nguyên triển khai dự án phòng chống HIV/AIDS, 2 năm cộng tác với WHO.
21/06/2023
Mặc định
Lớn hơn
Khạc đờm ra máu là một triệu chứng làm cho người bệnh cảm thấy hoang mang, lo lắng. Đây là dấu hiệu không nên bỏ qua, bởi nó có thể là cảnh báo của một số vấn đề sức khỏe nghiêm trọng như viêm phổi, ung thư phổi, ung thư vòm họng… và một số bệnh lý khác.
Bài viết này sẽ giải thích rõ hơn về các nguyên nhân dẫn đến triệu chứng khạc đờm ra máu và các biện pháp phòng ngừa cũng như điều trị hiệu quả nhất. Chúng tôi hy vọng thông tin trong bài viết sẽ giúp bạn có được cách xử trí phù hợp khi đối mặt với tình trạng này. Hãy cùng tìm hiểu nhé!
Khạc đờm là quá trình thải các chất đờm khỏi cơ thể thông qua phản xạ. Chất đờm thường là trong suốt hoặc hơi đục, nhưng đôi khi chúng có thể có màu đỏ tươi hoặc hồng. Có một số dạng khạc đờm ra máu phổ biến, bao gồm:

Tổn thương đường hô hấp trên:
Bệnh lý như viêm mũi, viêm amidan, viêm họng có thể làm tổn thương đường hô hấp trên của người bệnh. Điều này gây ra các triệu chứng đau rát họng, sưng phù và ứ máu trong niêm mạc họng. Khi người bệnh khạc đờm, áp lực có thể làm vỡ các mạch máu trong niêm mạc họng, gây ra sự kết hợp giữa máu và đờm.
Viêm thanh quản:
Khi người bệnh bị viêm thanh quản cấp và mạn tính, lớp niêm mạc của thanh quản sẽ bị tổn thương, trở nên mỏng và dễ bị sưng tấy. Khi dây thanh quản bị kích thích bởi khói, bụi hoặc các tác nhân khác, có thể gây ngứa rát ở cổ họng và gây ra các triệu chứng ho và khạc đờm có máu.
Viêm phế quản:
Là tình trạng viêm trong đường dẫn khí trong phổi, dẫn đến hẹp, co thắt và tắc nghẽn đường thở của người bệnh. Triệu chứng bao gồm đau họng, ho có đờm, thở khò khè và đờm có máu.
Nhiễm trùng:
Ngoài các triệu chứng như khó thở, sốt, đau đầu, bệnh nhân cũng có thể bị xuất hiện máu trong đờm do nhiễm trùng bởi vi khuẩn, virus hoặc nấm gây ra.
Viêm phổi:
Là tình trạng tổn thương các cấu trúc trong phổi, chủ yếu là phế nang, thường do tác nhân virus, vi khuẩn, nấm hoặc hóa chất độc hại gây ra. Triệu chứng thường gặp là ho nhiều, có đờm và đôi khi có máu trong đờm.

Giãn phế quản:
Là tình trạng làm cho máu thoát vào lòng phế quản, dần tích tụ lại và gây ra ho ra máu, có thể là máu đỏ tươi hoặc máu cục, máu đông.
Lao phổi:
Là bệnh lý gây ra triệu chứng ho ra máu. Bệnh nhân cũng có thể có các triệu chứng khác như giảm cân đột ngột không rõ nguyên nhân, đổ mồ hôi vào ban đêm, mệt mỏi và sốt về chiều.
Ung thư phổi:
Nếu khạc ra đờm có máu, người bệnh cần lưu ý về nguy cơ mắc ung thư phổi. Ngoài ra, các triệu chứng khác như thở khò khè, đau ngực, cảm giác chán ăn và mệt mỏi cũng cần được chú ý.
Ung thư vòm họng:
Người bệnh mắc ung thư vòm họng thường khạc ra đờm có máu, đau họng, cổ và tai hoặc cũng có thể bị sụt cân. Loại ung thư này là ác tính và có thể ảnh hưởng đến mọi lứa tuổi.

Một số xét nghiệm được chỉ định để hỗ trợ xác định nguyên nhân ho ra máu ở bệnh nhân như:
Dựa vào đặc điểm của đờm và máu có thể xác định một số tình trạng bệnh lý:
Sau khi xác định được nguyên nhân khạc đờm có máu, bác sĩ sẽ chỉ định các phương pháp thích hợp để điều trị như kê đơn kháng sinh (nguyên nhân là nhiễm khuẩn) hoặc phẫu thuật (nếu có khối u và cục máu đông…
Có nhiều nguyên nhân về bệnh lý có thể gây nên khạc đờm ra máu. Triệu chứng này có thể xuất hiện ở bất kỳ đối tượng nào và không phụ thuộc độ tuổi hay giới tính. Do đó chúng ta không nên chủ quan khi chẳng may gặp phải.
Để hỗ trợ điều trị khạc đờm ra máu, bên cạnh tuân thủ phác đồ điều trị của bác sĩ, người bệnh cần áp dụng các biện pháp sau đây:
Hy vọng rằng thông tin trong bài viết có thể giúp bạn hiểu rõ hơn về triệu chứng khạc đờm ra máu và các nguyên nhân, cách điều trị giúp cải thiện chất lượng cuộc sống. Đồng thời, có thể giúp bạn biết cách xử trí và hạn chế rủi ro khi gặp phải tình trạng này.
Ánh Tuyết
Nguồn tham khảo: medlatec.vn, hellobacsi.com
Dược sĩ Đại học Nguyễn Tuấn Trịnh
Từng làm ở Viện ISDS, nhiều năm cộng tác với CDC Thái Nguyên triển khai dự án phòng chống HIV/AIDS, 2 năm cộng tác với WHO.